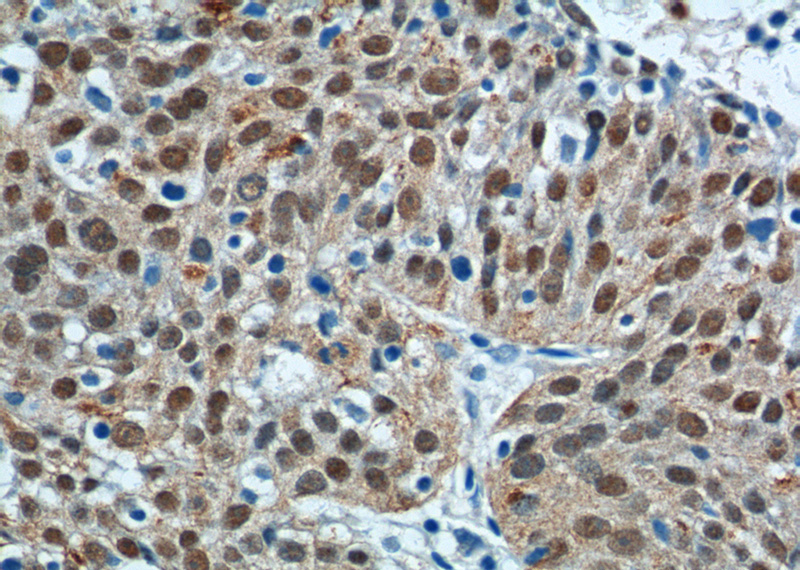
Immunohistochemistry of paraffin-embedded human lung cancer tissue slide using Catalog No:115515(SOX2 Antibody) at dilution of 1:200 (under 40x lens).

-
Product Name
SOX2 antibody
- Documents
-
Description
SOX2 Rabbit Polyclonal antibody. Positive IHC detected in human lung cancer tissue. Positive IF detected in human embronic stem cells, Zebrafish. Positive WB detected in Transfected HEK-293 cells. Observed molecular weight by Western-blot: 34 kDa-37 kDa
-
Tested applications
ELISA, IF, WB, IHC
-
Species reactivity
Human,Mouse,Rat,Zebrafish; other species not tested.
-
Alternative names
ANOP3 antibody; MCOPS3 antibody; SOX2 antibody; Transcription factor SOX 2 antibody
-
Isotype
Rabbit IgG
-
Preparation
This antibody was obtained by immunization of SOX2 recombinant protein (Accession Number: NM_003106). Purification method: Antigen affinity purified.
-
Clonality
Polyclonal
-
Formulation
PBS with 0.1% sodium azide and 50% glycerol pH 7.3.
-
Storage instructions
Store at -20℃. DO NOT ALIQUOT
-
Applications
Recommended Dilution:
WB: 1:2000-1:20000
IHC: 1:20-1:200
IF: 1:20-1:200
-
Validations

Confocal immunofluorescent analysis of human embronic stem cells with Catalog No:115515 at dilution of 1:50. The PE shows staining with Catalog No:115515/PE. The DAPI shows nuclear staining by DAPI.

IF result of anti-SOX2(Catalog No:115515) in Zebrafish by Dr. Caroline Parkin.

IF result of anti-SOX2 (Catalog No:115515) with the spine of zebrafish by Dr. Caroline.

IF result of anti-SOX2 (Catalog No:115515) whith the midbrain of zebrafish by Dr.Caroline.

IF result of anti-SOX2 (Catalog No:115515) whith the grey zone of zebrafish by Dr.Caroline.

Transfected HEK-293 cells were subjected to SDS PAGE followed by western blot with Catalog No:115515(SOX2 Antibody) at dilution of 1:5000
Immunohistochemistry of paraffin-embedded human lung cancer tissue slide using Catalog No:115515(SOX2 Antibody) at dilution of 1:200 (under 40x lens).
-
Background
Sox2, also known as SRY (sex determining region Y)-box 2, is a transcription factor essential for maintaining self-renewal of undifferentiated ES cells and is one of the key transcription factors used to reprogram mouse and human fibroblasts to a pluripotent state. Sox2 expressed in undifferentiated pluripotent stem cells and germ cells during development. Affinity purified rabbit anti-Sox2 antibody can be used to demonstrate pluripotency of ES and iPS cells. This antibody is a rabbit polyclonal antibody raised against an internal region of human SOX2.
-
References
- Piazzon N, Schlotter F, Lefebvre S. Implication of the SMN complex in the biogenesis and steady state level of the signal recognition particle. Nucleic acids research. 41(2):1255-72. 2013.
- Huang CF, Xu XR, Wu TF, Sun ZJ, Zhang WF. Correlation of ALDH1, CD44, OCT4 and SOX2 in tongue squamous cell carcinoma and their association with disease progression and prognosis. Journal of oral pathology & medicine : official publication of the International Association of Oral Pathologists and the American Academy of Oral Pathology. 43(7):492-8. 2014.
- Lu HX, Yang ZQ, Jiao Q. Low concentration of serum helps to maintain the characteristics of NSCs/NPCs on alkali-treated PHBHHx film in vitro. Neurological research. 36(3):207-14. 2014.
- Tao H, Li H, Su Y. Histone methyltransferase G9a and H3K9 dimethylation inhibit the self-renewal of glioma cancer stem cells. Molecular and cellular biochemistry. 394(1-2):23-30. 2014.
- Wang Y, He L, Du Y. The long noncoding RNA lncTCF7 promotes self-renewal of human liver cancer stem cells through activation of Wnt signaling. Cell stem cell. 16(4):413-25. 2015.
- Yang G, Jia Y, Li C, Cheng Q, Yue W, Pei X. Hyperglycemic Stress Impairs the Stemness Capacity of Kidney Stem Cells in Rats. PloS one. 10(10):e0139607. 2015.
- Wu Y, Shu J, He C. ROCK inhibitor Y27632 promotes proliferation and diminishes apoptosis of marmoset induced pluripotent stem cells by suppressing expression and activity of caspase 3. Theriogenology. 85(2):302-14. 2016.
Related Products / Services
Please note: All products are "FOR RESEARCH USE ONLY AND ARE NOT INTENDED FOR DIAGNOSTIC OR THERAPEUTIC USE"
